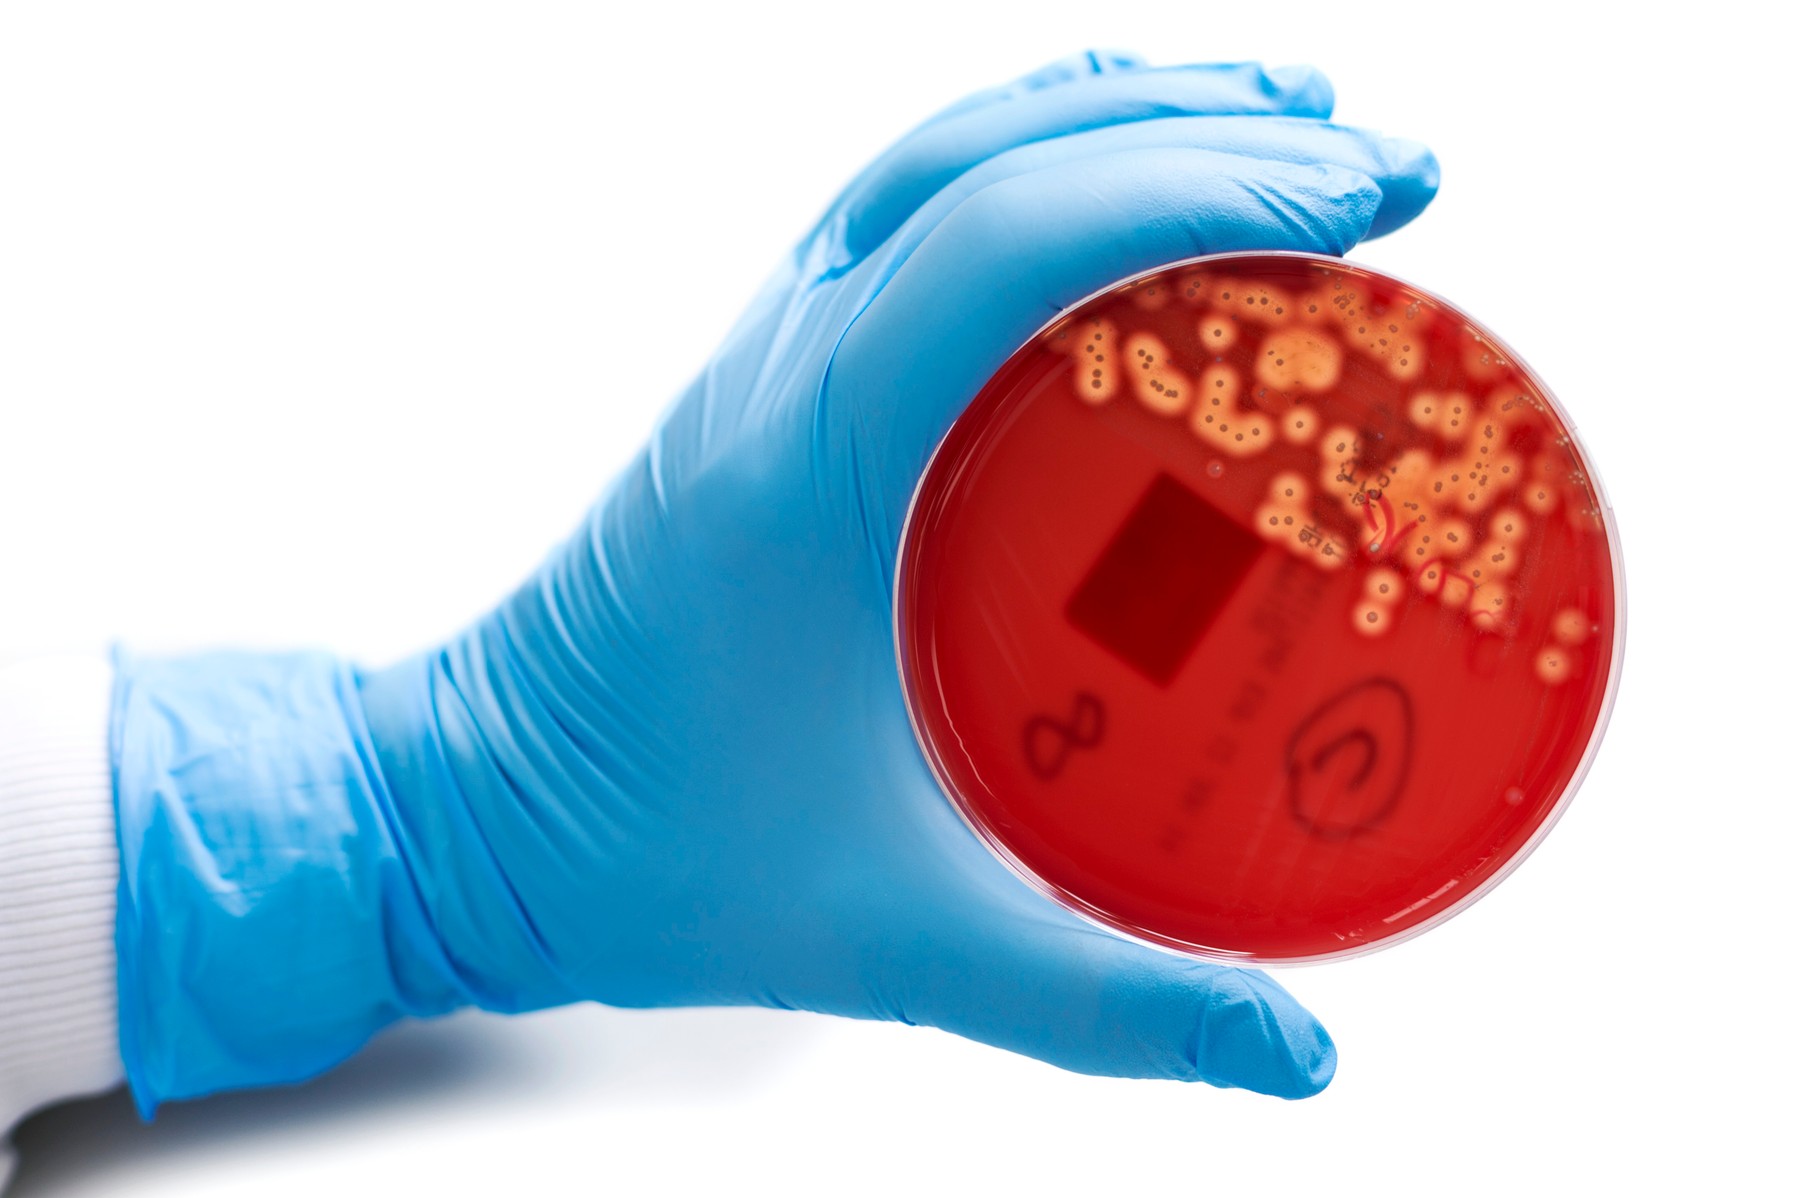
streptokok

V Veliki Britaniji je od 19. septembra zaradi okužb z bakterijo streptokok A umrlo najmanj 30 otrok. Samo v Angliji pa je zaradi te invazivne oblike bakterijske okužbe umrlo skupno 122 ljudi, kažejo podatki britanske agencije za zdravstveno varstvo (UKHSA).
Oglaševanje
V Angliji je zaradi okužb s streptokokom A umrlo že 25 oseb mlajših od 18 let. Na Severnem Irskem in v Walesu so skupaj umrli trije otroci, na Škotskem pa še dva. Britanska agencija za zdravstveno varstvo (UKHSA) je med 19. septembrom in 25. decembrom zabeležila 151 primerov okužb s streptokokom A pri otrocih, starih od enega do štirih let, v primerjavi s 194 primeri v isti starostni skupini v celotni sezoni 2017-2018 - zadnjem obdobju s podobno visoko stopnjo tovrstnih okužb.
Agencija je ob tem navedla, da okužbe z bakterijo ostajajo redke in da je večina primerov še vedno pri starejših od 45 let. Vseeno pa podatki kažejo na izvensezonsko povečanje okužb s streptokokom A in posledično na povečanje primerov škrlatinke in drugih bolezni, ki jih povzroča bakterija. Letos so namreč zabeležili že 33.836 primerov škrlatinke v primerjavi s 4672 primeri v istem obdobju v letih 2017-2018.
Okužbe s streptokokom se sicer zdravijo z antibiotiki, večina otrok ni huje prizadetih, v redkih primerih pa lahko pride do zapletov. Bakterija lahko med drugim privede do nekrotizirajočega fasciitisa, znanega tudi kot "bolezen, ki žre meso", in sindroma toksičnega šoka, ki lahko povzroči nizek krvni tlak in poškodbe organov.
Zakaj je število okužb večje kot navadno, ni jasno. Strokovnjaki menijo, da je to morda posledica dejstva, da so številni otroci zaradi ukrepov v času pandemije covida-19 razvili manjšo odpornost na patogene.
Spremljajte N1 na družbenih omrežjih Facebook, Instagram in Twitter.
Naložite si našo aplikacijo: na voljo za android in za iOS.
Kakšno je tvoje mnenje o tem?
Sodeluj v razpravi ali preberi komentarje
Oglaševanje
Kakšno je tvoje mnenje o tem?
Sodeluj v razpravi ali preberi komentarje
Oglaševanje
Najbolj brano
Oglaševanje
Oglaševanje
Najnovejše
Oglaševanje




 Srbija
Srbija
 Hrvatska
Hrvatska
 Bosna i Hercegovina
Bosna i Hercegovina




























































